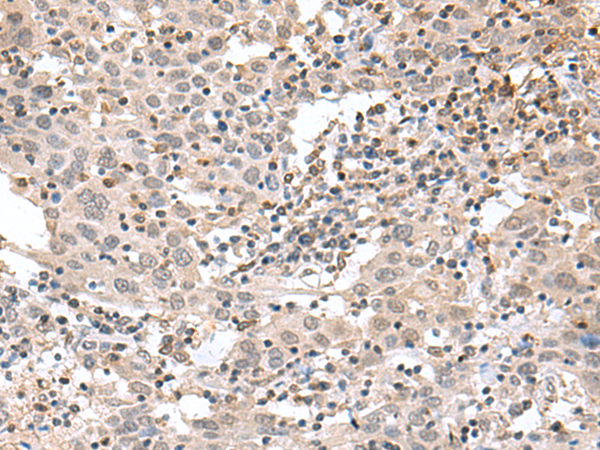

|
Background: |
This gene encodes a member of a superfamily of divalent cation-dependent phosphodiesterases. The encoded protein associates with CD40, tumor necrosis factor (TNF) receptor-75 and TNF receptor associated factors (TRAFs), and inhibits nuclear factor-kappa-B activation. This protein has sequence and structural similarities with APE1 endonuclease, which is involved in both DNA repair and the activation of transcription factors. |
|
Applications: |
ELISA, WB, IHC |
|
Name of antibody: |
TDP2 |
|
Immunogen: |
Synthetic peptide of human TDP2 |
|
Full name: |
tyrosyl-DNA phosphodiesterase 2 |
|
Synonyms: |
EAP2; AD022; EAPII; TTRAP; hTDP2; dJ30M3.3 |
|
SwissProt: |
O95551 |
|
ELISA Recommended dilution: |
5000-10000 |
|
IHC positive control: |
Human cervical cancer and Human thyroid cancer |
|
IHC Recommend dilution: |
50-300 |
|
WB Predicted band size: |
41 kDa |
|
WB Positive control: |
Mouse small intestines tissue lysate |
|
WB Recommended dilution: |
500-2000 |

購物車
幫助
021-54845833/15800441009
